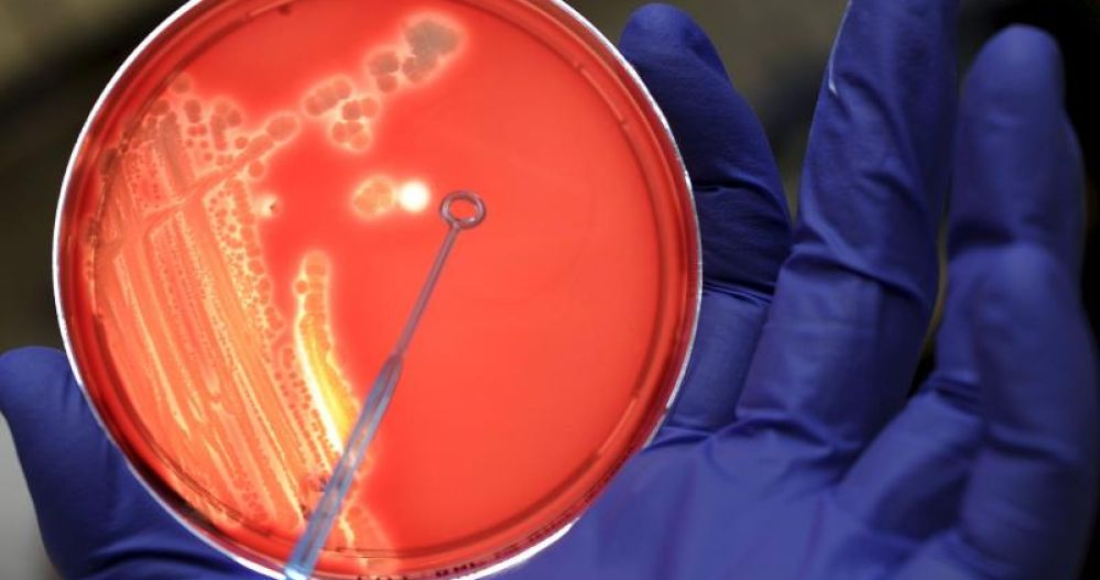

“Con este proceso se consigue convertir el cuerpo de nuevo en una sustancia muy beneficiosa: el suelo, la tierra”, menciona Seth Viddal, copropietario de The Natural Funeral.
Por Thomas Peipert
LAFAYETTE, Colorado, EU, 17 de septiembre (AP) — En un almacén en los alrededores de Denver, situado entre un taller de reparación de automóviles y un negocio de reciclaje de computadoras, Seth Viddal se las arregla con la vida y la muerte.
Él y uno de sus empleados han construido un recipiente que esperan marque el comienzo de una era más ecológica de la ciencia mortuoria que incluya la descomposición orgánica natural de los restos humanos, también conocida como compostaje humano.
“Se trata de un proceso natural en el que el cuerpo es devuelto a un nivel elemental en un periodo corto", dijo Viddal, que comparó la práctica con el compostaje de restos de comida y residuos de jardinería en el patio trasero.
“Se trata del mismo proceso, pero realizado con un cuerpo humano dentro de un contenedor y, en nuestro caso, en un entorno controlado”.

El 7 de septiembre, Colorado se convirtió en el segundo estado, después de Washington, en permitir el compostaje de cuerpos humanos.
El estado de Oregon permitirá esta práctica a partir de julio del próximo año.
En Washington, los tres negocios con licencia para compostar restos humanos han transformado al menos 85 cuerpos desde que la ley entró en vigor en mayo de 2020, y más de 900 personas han contratado el servicio a medida que los funerales naturales se vuelven más populares.
Viddal, que es copropietario de The Natural Funeral en Lafayette, presionó a la Legislatura de Colorado para que se adoptara esta opción y comenzó a construir un prototipo de recipiente en una zona industrial poco después de que el proyecto de ley bipartidista se convirtiera en ley.
Basada en un diseño que se utiliza en Washington, la caja de madera aislante mide unos dos metros (siete pies) de largo, un metro (tres pies) de ancho y un metro (tres pies) de profundidad. Está forrada con material impermeable y llena de virutas de madera y paja.
Las dos grandes ruedas de los extremos permiten desplazarla, lo que proporciona la oxigenación, agitación y absorción necesarias para que un cuerpo se convierta en abono.


Viddal considera este proceso como una “opción ecológica emocionante”, en el cual, además, ve vida en la muerte.
“El compostaje en sí mismo es una función muy activa y la realizan organismos vivos... Hay miles de millones de microbios vivos en nuestro tracto digestivo y en nuestro cuerpo. Y cuando nuestra vida cesa, la vida de esos microbios no desaparece”, explica.
Al cabo de unos tres meses, se abre el recipiente y se filtra la “tierra” para retirar dispositivos médicos como prótesis o marcapasos.
Los huesos grandes que aún quedan se pulverizan y se devuelven al recipiente para otros tres meses de compostaje.
Los dientes se retiran para evitar la contaminación por el mercurio de los empastes.
El recipiente debe alcanzar los 55 grados Celsius (131° Fahrenheit) durante 72 horas continuas para matar cualquier bacteria o patógeno.
La temperatura elevada se produce de forma natural durante la descomposición del cuerpo en una caja cerrada.


En seis meses, el cuerpo, las virutas de madera y la paja se transformarán en suficiente tierra para llenar la batea de una pickup.
Los familiares pueden conservar la tierra para esparcirla en sus patios, pero la ley de Colorado prohíbe venderla y utilizarla comercialmente para cultivar alimentos para el consumo humano. Sólo permite a las funerarias y crematorios con licencia compostar cuerpos humanos.
“Con este proceso se consigue convertir el cuerpo de nuevo en una sustancia muy beneficiosa: el suelo, la tierra”, dice Viddal, que tiene previsto construir más de 50 recipientes para el compostaje de cuerpos.
The Natural Funeral cobra 7 mil 900 dólares por el compostaje de cuerpos, comparados con 2 mil 200 dólares que cuesta una cremación, aunque Viddal señala que un entierro y servicio tradicionales en la zona de Denver pueden superar los 10 mil dólares.